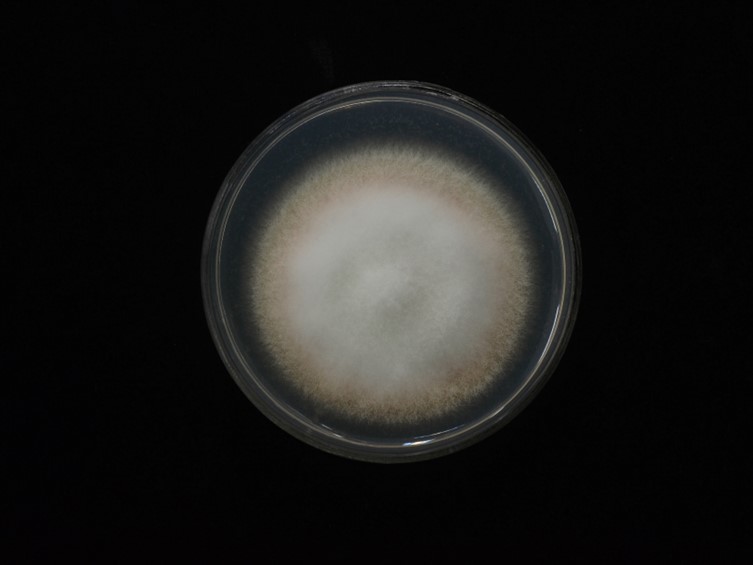

Holotype:
THAILAND, Khon Kaen Province, Phu Wiang National Park, 17 Jul. 2017, S. Mongkolsamrit, W. Noisripoom, K. Tasanathai, W. Himaman, B. Sakolrak, P. Jangsantear, holotype BBH 47774, ex-type living culture BCC 85066.
Habitat:
Leaf litter.
Host:
Spider cocoons.
Description:
 Stromata solitary or multiple arising from spider cocoons, 4-8 mm long and 0.5 mm broad, pale orange,
cylindrical to enlarging apically. Fertile part orange to reddish-orange, clavate, elliptical to fusiform, 2.5-
5 mm long, 1-2 mm broad.
Stromata solitary or multiple arising from spider cocoons, 4-8 mm long and 0.5 mm broad, pale orange,
cylindrical to enlarging apically. Fertile part orange to reddish-orange, clavate, elliptical to fusiform, 2.5-
5 mm long, 1-2 mm broad.  Perithecia semi-immersed, narrowly ovoid, 450-500 × 150-200 μm.
Perithecia semi-immersed, narrowly ovoid, 450-500 × 150-200 μm.  Asci cylindrical, eightspored, 60-250 × 2-2.5 μm. Ascospores hyaline, whole, bola-shaped, 250-400 μm, central part filiform, 0.3 μm broad, terminal part narrowly fusiform, with 3- or 4-septa, 30-65 × 0.5 μm. Anamorph: Conidial arrangement, evlachovaea-like.
Asci cylindrical, eightspored, 60-250 × 2-2.5 μm. Ascospores hyaline, whole, bola-shaped, 250-400 μm, central part filiform, 0.3 μm broad, terminal part narrowly fusiform, with 3- or 4-septa, 30-65 × 0.5 μm. Anamorph: Conidial arrangement, evlachovaea-like.
Culture characteristics:
Colony on PDA attaining a diam of 30 mm in 10 d, cottony with high mycelium density, orange pink at the colony edges, white in the middle. Phialides arising from aerial hyphae, solitary, or in whorls of two to three on each branch, 5–8 × 1.5–2 μm, swollen at the base tapering into the apex. Conidia hyaline, fusoid to ovoid, smooth, one-celled, 3–5 × 1–2 μm.
Colony on PDA attaining a diam of 30 mm in 10 d, cottony with high mycelium density, orange pink at the colony edges, white in the middle. Phialides arising from aerial hyphae, solitary, or in whorls of two to three on each branch, 5–8 × 1.5–2 μm, swollen at the base tapering into the apex. Conidia hyaline, fusoid to ovoid, smooth, one-celled, 3–5 × 1–2 μm.
Reference:
Mongkolsamrit S, Noisripoom W, Tasanathai K, et al. (2020). Molecular phylogeny and morphology reveal cryptic species in Blackwellomyces and Cordyceps (Cordycipitaceae) from Thailand. Mycological Progress 19: 957–983.
DOI: https://doi.org/10.1007/s11557-020-01615-2Species |
Strain |
Compound |
Pubchem CID |
Biological activity |
Reference |
|---|
|
Strain |
ITS | LSU | RPB1 | RPB2 | TEF1 |
|---|---|---|---|---|---|
| BCC 85065 | MT000702 | MT003037 | MT017810 | MT017828 | MT017850 |
| BCC 85066 | MT000703 | MT003038 | MT017811 | MT017829 | MT017851 |
| BCC 88291 | MT000704 | MT003039 | MT017812 | MT017830 | MT017852 |